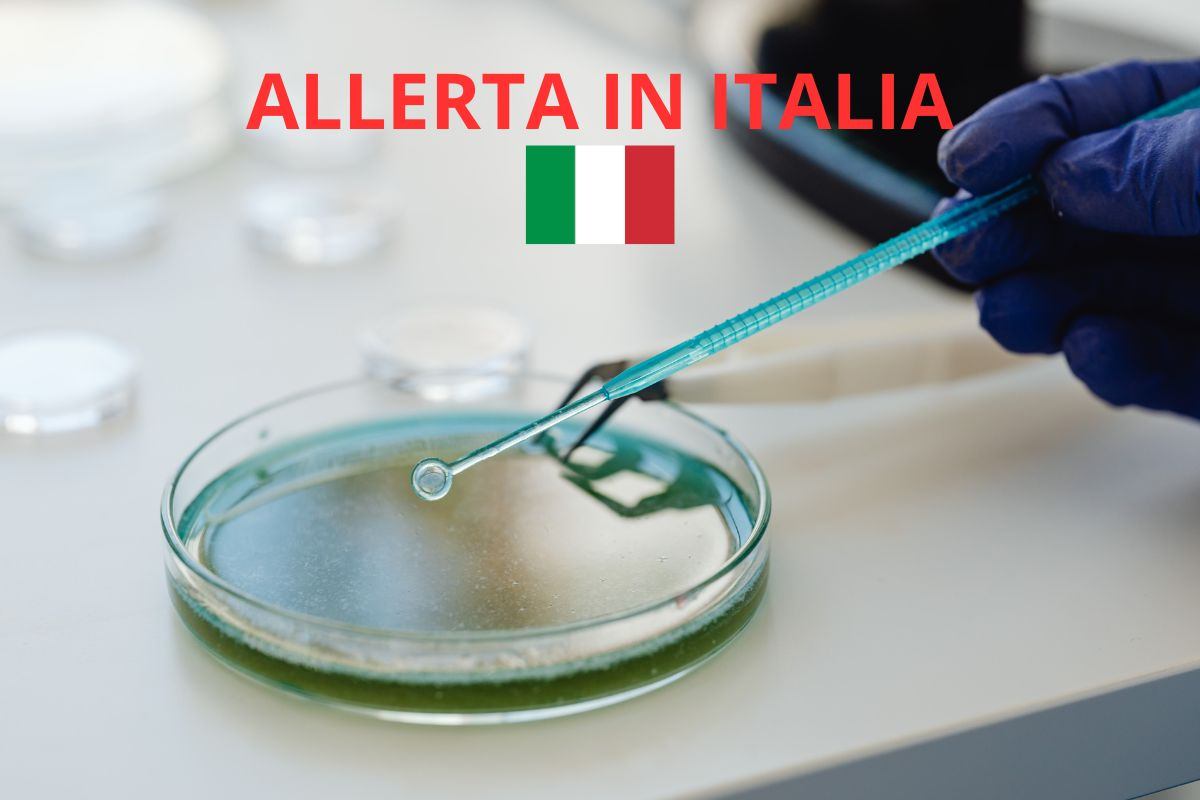
analisi di laboratorio, scritta allerta in italia e bandiera italiana

Ci sono pericoli che fanno rumore, che attirano subito l’attenzione e che sappiamo riconoscere: un corto circuito, una fuga di gas, un elettrodomestico difettoso.
E poi ce ne sono altri, molto più subdoli. Silenziosi, invisibili, quotidiani. Vivono con noi senza farsi notare e, proprio per questo, riescono a passare inosservati per anni. Non hanno odore immediato, non causano allarmi improvvisi e non compaiono nelle checklist di sicurezza domestica.
Eppure, secondo diversi studi, possono incidere direttamente sulla salute di chi vive in casa, soprattutto dei più fragili. Il punto più inquietante?Non si trovano all’esterno, né arrivano da fuori. Sono già dentro le nostre abitazioni.
Quello che non vediamo (ma che usiamo ogni giorno)
Ogni casa è fatta di spazi visibili e di una rete nascosta che lavora ininterrottamente: tubazioni, scarichi, condotti. È qui che spesso si accumulano residui organici, umidità e calore, creando un ambiente ideale per qualcosa che raramente viene preso in considerazione.
All’inizio i segnali sono impercettibili:
-
uno scarico leggermente più lento
-
un rumore insolito
-
un odore che compare e scompare
Piccoli dettagli che tendiamo a ignorare, convinti che non siano nulla di serio. Ed è proprio in questa fase che il problema inizia a consolidarsi.
Ecco cosa si nasconde davvero negli scarichi
Il vero protagonista di questa storia ha un nome poco conosciuto, ma è molto più diffuso di quanto immaginiamo: il biofilm. Si tratta di aggregati di batteri e microrganismi che si organizzano in una sorta di pellicola viscosa, aderendo alle superfici umide. Secondo la definizione della Treccani, il biofilm è un ecosistema autonomo, capace di proteggersi e rafforzarsi nel tempo.

Gli scarichi di lavandini, docce e WC rappresentano l’habitat perfetto:
acqua stagnante, residui di sapone, capelli, pelle morta, resti organici. Una combinazione ideale per la proliferazione microbica.
Perché il biofilm è più pericoloso di quanto sembri
Uno studio dell’Università dell’East Anglia di Norwich ha evidenziato un aspetto spesso sottovalutato: gli schizzi d’acqua provenienti da scarichi contaminati possono diffondere batteri nell’ambiente domestico.
Questo significa che un semplice gesto quotidiano può contribuire alla dispersione di microrganismi potenzialmente dannosi, con rischi maggiori per:
-
bambini
-
anziani
-
persone con difese immunitarie basse
Il problema non è solo igienico. Il biofilm è estremamente resistente: la sua struttura lo rende difficile da eliminare con i normali detergenti, permettendogli di sopravvivere e rafforzarsi nel tempo.
Prevenzione domestica: piccoli gesti che fanno la differenza
La buona notizia è che non servono interventi drastici. La prevenzione è semplice, economica e alla portata di tutti.
Tra le buone abitudini più efficaci:
-
evitare di gettare oli, capelli e residui di cibo negli scarichi
-
installare griglie protettive
-
effettuare una pulizia regolare delle tubature
Un rimedio naturale molto usato consiste nel versare bicarbonato di sodio seguito da aceto bianco: una reazione semplice che aiuta a sciogliere i residui e a limitare la formazione del biofilm. In alternativa, esistono detergenti ecologici specifici, efficaci senza danneggiare l’ambiente.
I segnali da non ignorare Il biofilm non compare all’improvviso. Avvisa, ma lo fa in modo discreto. Attenzione se noti:
-
cattivi odori persistenti
-
scarichi lenti
-
gorgoglii frequenti
Intervenire subito può evitare problemi sanitari e costosi interventi di disostruzione.
La vera sicurezza domestica parte da ciò che non si vede, prendersi cura della casa oggi non significa solo pulire le superfici o scegliere prodotti sostenibili. Significa sviluppare una nuova consapevolezza, anche verso ciò che resta nascosto.
Le tubature sono una parte essenziale del nostro benessere quotidiano. Ignorarle significa lasciare spazio a un rischio silenzioso, ma prevenibile. Perché, spesso, la vera sicurezza non è dove guardiamo sempre, ma proprio dove non guardiamo mai.





